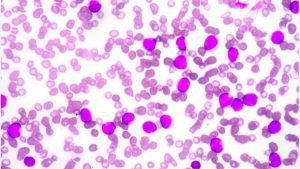
Aplastic Anemia Treatment in India

Unlock Exclusive Discount : Your Gateway to Premium Healthcare with Medsurge India Health Value Card.

Unlock Exclusive Discount : Your Gateway to Premium Healthcare with Medsurge India Health Value Card.


Blood is a body fluid that keeps us alive. It carries oxygen and essential nutrients to all parts of the…

Myelodysplastic Syndrome Treatment in India is done at an affordable cost by the best doctors and at top-class centres. Through…

Lymphoma is cancer that occurs in the lymphatic system – an integral part of the immune system responsible for fighting…

Non-Hodgkin lymphoma is cancer that happens in the lymphatic system of the body. When a person is going through this…
When the sticky substance inside the bones called bone marrow gets altered and is not able to make platelets, white…

White blood cells are the protectors of the body; the lymphocytes are types of white blood cells that help to…

Thalassemia is a rare disease that once caused to someone, affects the production of hemoglobin in their body. Hemoglobin helps…

Do you know what bone marrow does for your body? It produces blood cells like red blood cells, white blood…

Sickle cell anemia is a blood disorder affecting a lot of people of all ages. It’s passed down by genes…

Sickle cell anemia is a disorder in which the red blood cells become misshaped and crumble down. It is named…
By using our site, you agree to our Terms and Conditions, Privacy Policy and Refund Policy. Medsurge India provides reliable healthcare information and treatment options to support informed decision-making. Our content is designed to support and complement the guidance of your treating doctor, helping you feel informed and confident throughout your healthcare journey. We also Accept International Payments.

Copyright © 2025 NSM ONLINE SOLUTIONS PRIVATE LIMITED. All rights reserved.

